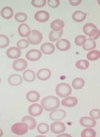
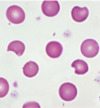

Anemi Flashcards
(102 cards)
Definition av anemi?
- B-Hb < 120 g/L kvinnor
- B-Hb < 130 g/L män
- Egentligen bättre att definiera utefter ”signifikant lägre för individen i förhållande till dennes normalvärde” eftersom
- Med tanke på att 2,5% av befolkningen normalt ligger utanför referensintervallet åt båda håll (vid normalfördelning) så kan vissa ligga utanför referens och ändå vara friska
- Det är ett symptom
Vilka är de tre orsakerna till anemi?
Förlust av erytrocyter
Problem med erytrocytfunktion
Problem med erytrocytproduktion
Hur ser förloppet ut vid förlust av erytrocyter och vad kan vara upphov till det?
-
Ofta mer plötslig
- Blödning
- Hemolys (immunmedierad eller mekanisk)
Vad kan vara orsaken till problem med erytrotcytfunktionen, vad kan problemen gälla och när ska vi börja misstänka det?
- Ofta ärftlig och kan gälla
- Membrandefekter
- Enzymdefekter
- Hemoglobinopatier
- Upptäcks tidigt genom att tillväxtkurvan avviker eller att neonatal ikterus kvarstår som ett tecken på hemolys
Hur utvecklar sig problem med erytrocytproduktionen och vad kan det bero på?
- Ofta långsamt utvecklande och diffusa symptom till en början
- Benmärgdysfunktion
- Brist på komponenter för erytropoes (EPO, järn, folat och B12), en ökad omsättning (blödning) kan också leda till brist på komponenter
Vad innebär MCV?
Volymindex

Vad innebär MCH och hur räknar vi ut det?
Färgindex
Hb/EPK

Vad innebär MCHC och hur kan vi räkna på det?
Mättnadsindex
Hb/EVF eller Hb/(EPK*MCV

Vad innebär EVF?
Erytrocyt volymfraktion
Vad innebär EPK?
Erytrocyt partikelkoncentration
När kan vi se en normocytär anemi (MCV 82-98)?
Förlust av erytrocyter
Sekundär anemi
Minskad produktion av erytrocyter
När kan vi se en förlust av erytrocyter?
- Ex akut blödning. Benmärg hinner inte kompensera, patienten ofta påverkad
När kan vi se en sekundär anemi?
- Kronisk inflammation – minskad produktion av erytrocyter genom hämning av erytropoesen via inflammatoriska cytokiner vilka även leder till stimulering av hepcidinsyntesen som i sin tur hämmar järntransport över membran.
- Malignitet – tumören konsumerar mer blodceller via ökad angiogenes samtidigt som en tumörsjukdom leder till ökad inflammatorisk aktivitet.
- Lever/njursvikt – syntes av viktiga faktorer för erytropoetiskaktivitet såsom EPO som huvudsakligen syntetiseras i njuren men även i levern och ökad mängd hepcidin från levern
När kan vi se en minskad produktion av erytrocyter?
- Vid en primär benmärgssjukdom drabbas ofta erytropoesen genom störd proliferation till följd av antingen defekta signalvägar eller undanträngd erytropoespå grund av malign överproduktion i andra cellinjer
- Aplastisk anemi – benmärg underproducerar
- Annan benmärgssjukdom med påverkad erytropoes
När kan vi se en mikrocytär anemi (MCV < 82)?
Järnbrist
Hemolytiska anemier (vissa)
Hemoglobinpatier
Vad kan orsaka en järnbrist?
- Långvariga mindre blödningar (mag/tarm, menstruationer)
- Ökat järnbehov (graviditet)
- Diet/svält
- Nedsatt absorption i tarm
Hur kan vissa av de hemolytiska anemierna orsaka mikrocytär anemi (MCV < 82)?
Vad brukar också kunna ses i samband med detta gällande storlek?
- Erytrocytfragmentering, dvs att erytrocyterna går sönder men kan ”repareras” i mjälten och åter komma ut i cirkulationen som en mindre cell. Ofta ses då olika stora erytrocyter, s.k. anisocytosom man studerar den röda blodbilden i mikroskop men medelcellvolymen är sänkt
Vilka tillstånd av hemoglobinpatier kan ge mikrocytär anemi?
Thalassemi och Sickle cell anemi (vid hypoxi)
När kan vi se en makrocytär anemi (MCV > 98)?
Megaloblastanemi (DNA-syntesen och därigenom differentieringen i benmärgen är påverkad)
Icke megaloblastanemi (DNA-syntesen är opåverkad och erytrocyterna är förstorade av andra orsaker)
Vad är påverkat vid megaloblastanemi?
DNA-syntesen och därigenom differentieringen i benmärgen är påverkad. Erytrocyterna har hög cellnybildning så de påverkas mkt
Vad kan orsaka megaloblastanemi?
B12-brist
Folatbrist
Behandling med folsyraantagonist
Vad beror en icke megaloblastanemi på, ge exempel också?
- DNA-syntesen är opåverkad och erytrocyterna är förstorade av andra orsaker
- Alkoholmissbruk
- Leversjukdom
- Myelodysplastisk syndrom
- Hypothyreros
Hur kan alkoholmissbruk ge icke megaloblastanemi?
- Benmärgstoxisk och ren membran-effekt av alkoholen som lösningsmedel. Till en början lätt förhöjt MCV men utvecklar vid gravt missbruk även en megaloblastanemi p.g.a. kombination med slemhinneatrofi i magtarmkanalen (försämrat upptag) och ofta även en dietär brist
Vilka är de kliniska fynden vid blodbrist och vad beror de på?
- Blekhet (beror på minskning av hemoglobin)
- Takykadi, blåsljud, hjärtsviktstecken (sent), hypotoni
- Ikterus (vid hemolys, kanske leversvikt i första hand)
- Munslemhinna (stor omsättning på celler)
- Munvinkelragader (järnbrist, B12-brist)
- Atrofisk tungslemhinna (B12-brist)
- Nedsatt vibrationssinne och reflexer (långvarig B12-brist)
- Metionin viktig vid myelinsyntes